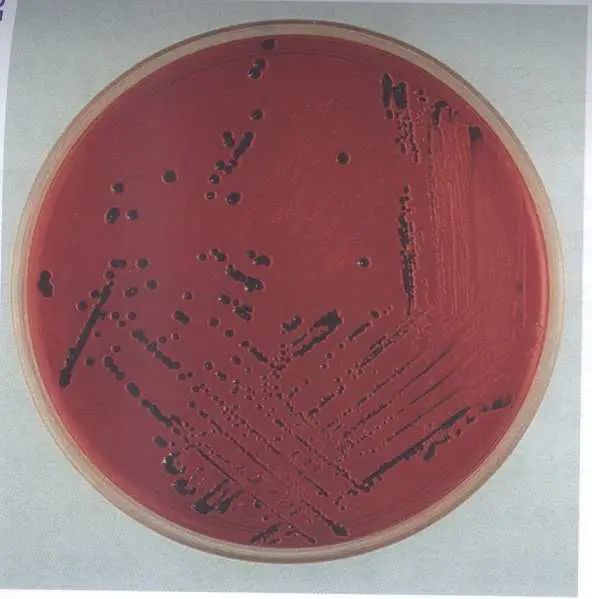
圖片

108年:(醫檢)微生(1)
下列何種⾰蘭⽒陰性菌在 XLD 培養基中呈現下圖之菌落型態?
A傷寒沙⾨⽒桿菌( Salmonella Typhi )
B沙雷⽒黏質桿菌( Serratia marcescens )
C宋內志賀⽒桿菌( Shigella sonnei )
D奇異變形桿菌( Proteus mirabilis )
詳細解析
本題觀念:
XLD(Xylose Lysine Deoxycholate)培養基是專門用於分離與鑑別腸道革蘭氏陰性菌的選擇性差異培養基,特別能有效區分 Salmonella、Shigella 及其他腸道菌。本題考核各菌在 XLD 上的菌落特徵,尤其是色素反應與硫化氫()產生所造成的黑色中心。
影像分析:
圖片為 XLD 培養基培養板(紅色背景),可見大量菌落分佈於培養基上,具有以下典型特徵:
- 菌落顏色:菌落呈粉紅色至紅色,與培養基背景色相近但略深。
- 黑色中心(black center):幾乎每個菌落均呈現明顯的黑色中心,部分菌落黑色佔比較大,甚至整體菌落外觀呈黑色點狀。
- 菌落大小:菌落大小適中,分佈均勻,有單離菌落亦有密集生長區域。
此影像呈現的「紅色/粉紅色菌落 + 黑色中心」正是 Salmonella 在 XLD 培養基上的典型表現,尤其符合傷寒沙門氏桿菌(Salmonella Typhi)的外觀特徵。
選項分析
(A) 傷寒沙門氏桿菌(Salmonella Typhi) Salmonella 在 XLD 上的關鍵特徵:
- 不發酵木糖(xylose)(或發酵後快速耗盡,接著利用 lysine decarboxylase 產生鹼性反應) → 菌落呈
...(解析預覽)...

升級 VIP 解鎖圖文解析